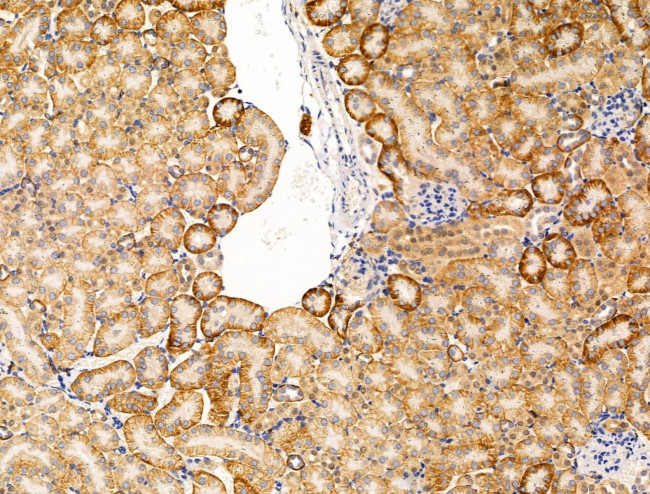
Spectrin alpha-1 Antibody in Immunohistochemistry (Paraffin) (IHC (P))

Search
Invitrogen
Spectrin alpha-1 Polyclonal Antibody
{{$productOrderCtrl.translations['antibody.pdp.commerceCard.promotion.promotions']}}
{{$productOrderCtrl.translations['antibody.pdp.commerceCard.promotion.viewpromo']}}
{{$productOrderCtrl.translations['antibody.pdp.commerceCard.promotion.promocode']}}: {{promo.promoCode}} {{promo.promoTitle}} {{promo.promoDescription}}. {{$productOrderCtrl.translations['antibody.pdp.commerceCard.promotion.learnmore']}}
图: 1 / 4
Spectrin alpha-1 Antibody (PA5-114843) in IHC (P)




Please note: We are reviewing Western blot images included in the antibody testing data in our catalog, including those provided by third parties. Unless expressly labeled or annotated as “raw-unedited”, Western blot images included in the antibody testing data in our catalog may have been edited, optimized or otherwise adjusted for presentation.
产品信息
PA5-114843
种属反应
宿主/亚型
分类
类型
抗原
偶联物
形式
浓度
规格
纯化类型
保存液
内含物
保存条件
运输条件
RRID
产品详细信息
Antibody detects endogenous levels of total alpha 1 Spectrin.
靶标信息
Spectrin is an actin crosslinking and molecular scaffold protein that links the plasma membrane to the actin cytoskeleton, and functions in the determination of cell shape, arrangement of transmembrane proteins, and organization of organelles. It is a tetramer made up of alpha-beta dimers linked in a head-to-head arrangement. This gene is one member of a family of alpha-spectrin genes. The encoded protein is primarily composed of 22 spectrin repeats which are involved in dimer formation. It forms weaker tetramer interactions than non-erythrocytic alpha spectrin, which may increase the plasma membrane elasticity and deformability of red blood cells. Mutations in this gene result in a variety of hereditary red blood cell disorders, including elliptocytosis type 2, pyropoikilocytosis, and spherocytic hemolytic anemia. [provided by RefSeq, Jul 2008]
仅用于科研。不用于诊断过程。未经明确授权不得转售。
篇参考文献 (0)
生物信息学
蛋白别名: alpha-spectrin 1, erythroid; Erythroid alpha-spectrin; erythroid spectrin alpha; hemolytic anemia; neuroscience mutagenesis facility, 4; spectrin alpha 1; spectrin alpha chain, erythrocyte; Spectrin alpha chain, erythrocytic 1; spectrin, alpha, erythrocytic 1 (elliptocytosis 2); spherocytosis
基因别名: AF093576; AI451697; ha; ihj; nmf4; sph; Spna-1; Spna1; SPTA; SPTA1
UniProt ID: (Mouse) P08032
Entrez Gene ID: (Rat) 289257, (Mouse) 20739